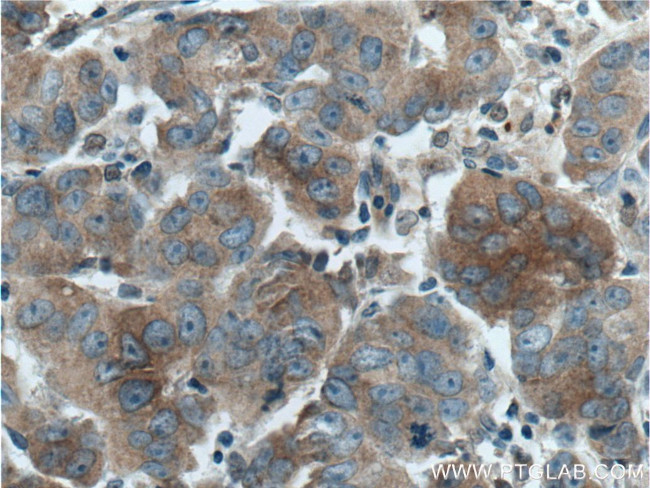
DVL1 Antibody in Immunohistochemistry (Paraffin) (IHC (P))

Search
Proteintech
DVL1 Polyclonal Antibody
{{$productOrderCtrl.translations['antibody.pdp.commerceCard.promotion.promotions']}}
{{$productOrderCtrl.translations['antibody.pdp.commerceCard.promotion.viewpromo']}}
{{$productOrderCtrl.translations['antibody.pdp.commerceCard.promotion.promocode']}}: {{promo.promoCode}} {{promo.promoTitle}} {{promo.promoDescription}}. {{$productOrderCtrl.translations['antibody.pdp.commerceCard.promotion.learnmore']}}
产品信息
27384-1-AP
种属反应
已发表种属
宿主/亚型
分类
类型
抗原
偶联物
形式
浓度
规格
纯化类型
保存液
内含物
保存条件
运输条件
产品详细信息
Immunogen sequence: LGQGYPYQY PGPPPCFPPA YQDPGFSYGS GSTGSQQSEG SKSSGSTRSS RRAPGREKER RAAGAGGSGS ESDHTAPSGV GSSWRERPAG QLSRGSSPRS QASATAPGLP PPHPTTKAYT VVGGPPGGPP VRELA (283-416 aa encoded by BC050454)
靶标信息
DVL1, the human homolog of the Drosophila dishevelled gene (dsh) encodes a cytoplasmic phosphoprotein that regulates cellproliferation, acting as a transducer molecule for developmentalprocesses, including segmentation and neuroblast specification.DVL1 is a candidate gene for neuroblastomatous transformation. TheSchwartz-Jampel syndrome and Charcot-Marie-Tooth disease type 2Ahave been mapped to the same region as DVL1. The phenotypes ofthese diseases may be consistent with defects which might beexpected from aberrant expression of a DVL gene during development.
仅用于科研。不用于诊断过程。未经明确授权不得转售。
生物信息学
蛋白别名: dishevelled 1 (homologous to Drosophila dsh); dishevelled, dsh homolog 1; Dishevelled-1; Dishevelled-1-like; DSH homolog 1; DSH homolog 1-like; MGC54245; RP5-890O3.5; Segment polarity protein dishevelled homolog DVL-1; unnamed protein product
基因别名: DRS2; DVL; DVL1; DVL1L1; DVL1P1; mKIAA4029
UniProt ID: (Human) O14640, (Mouse) P51141
Entrez Gene ID: (Human) 1855, (Mouse) 13542